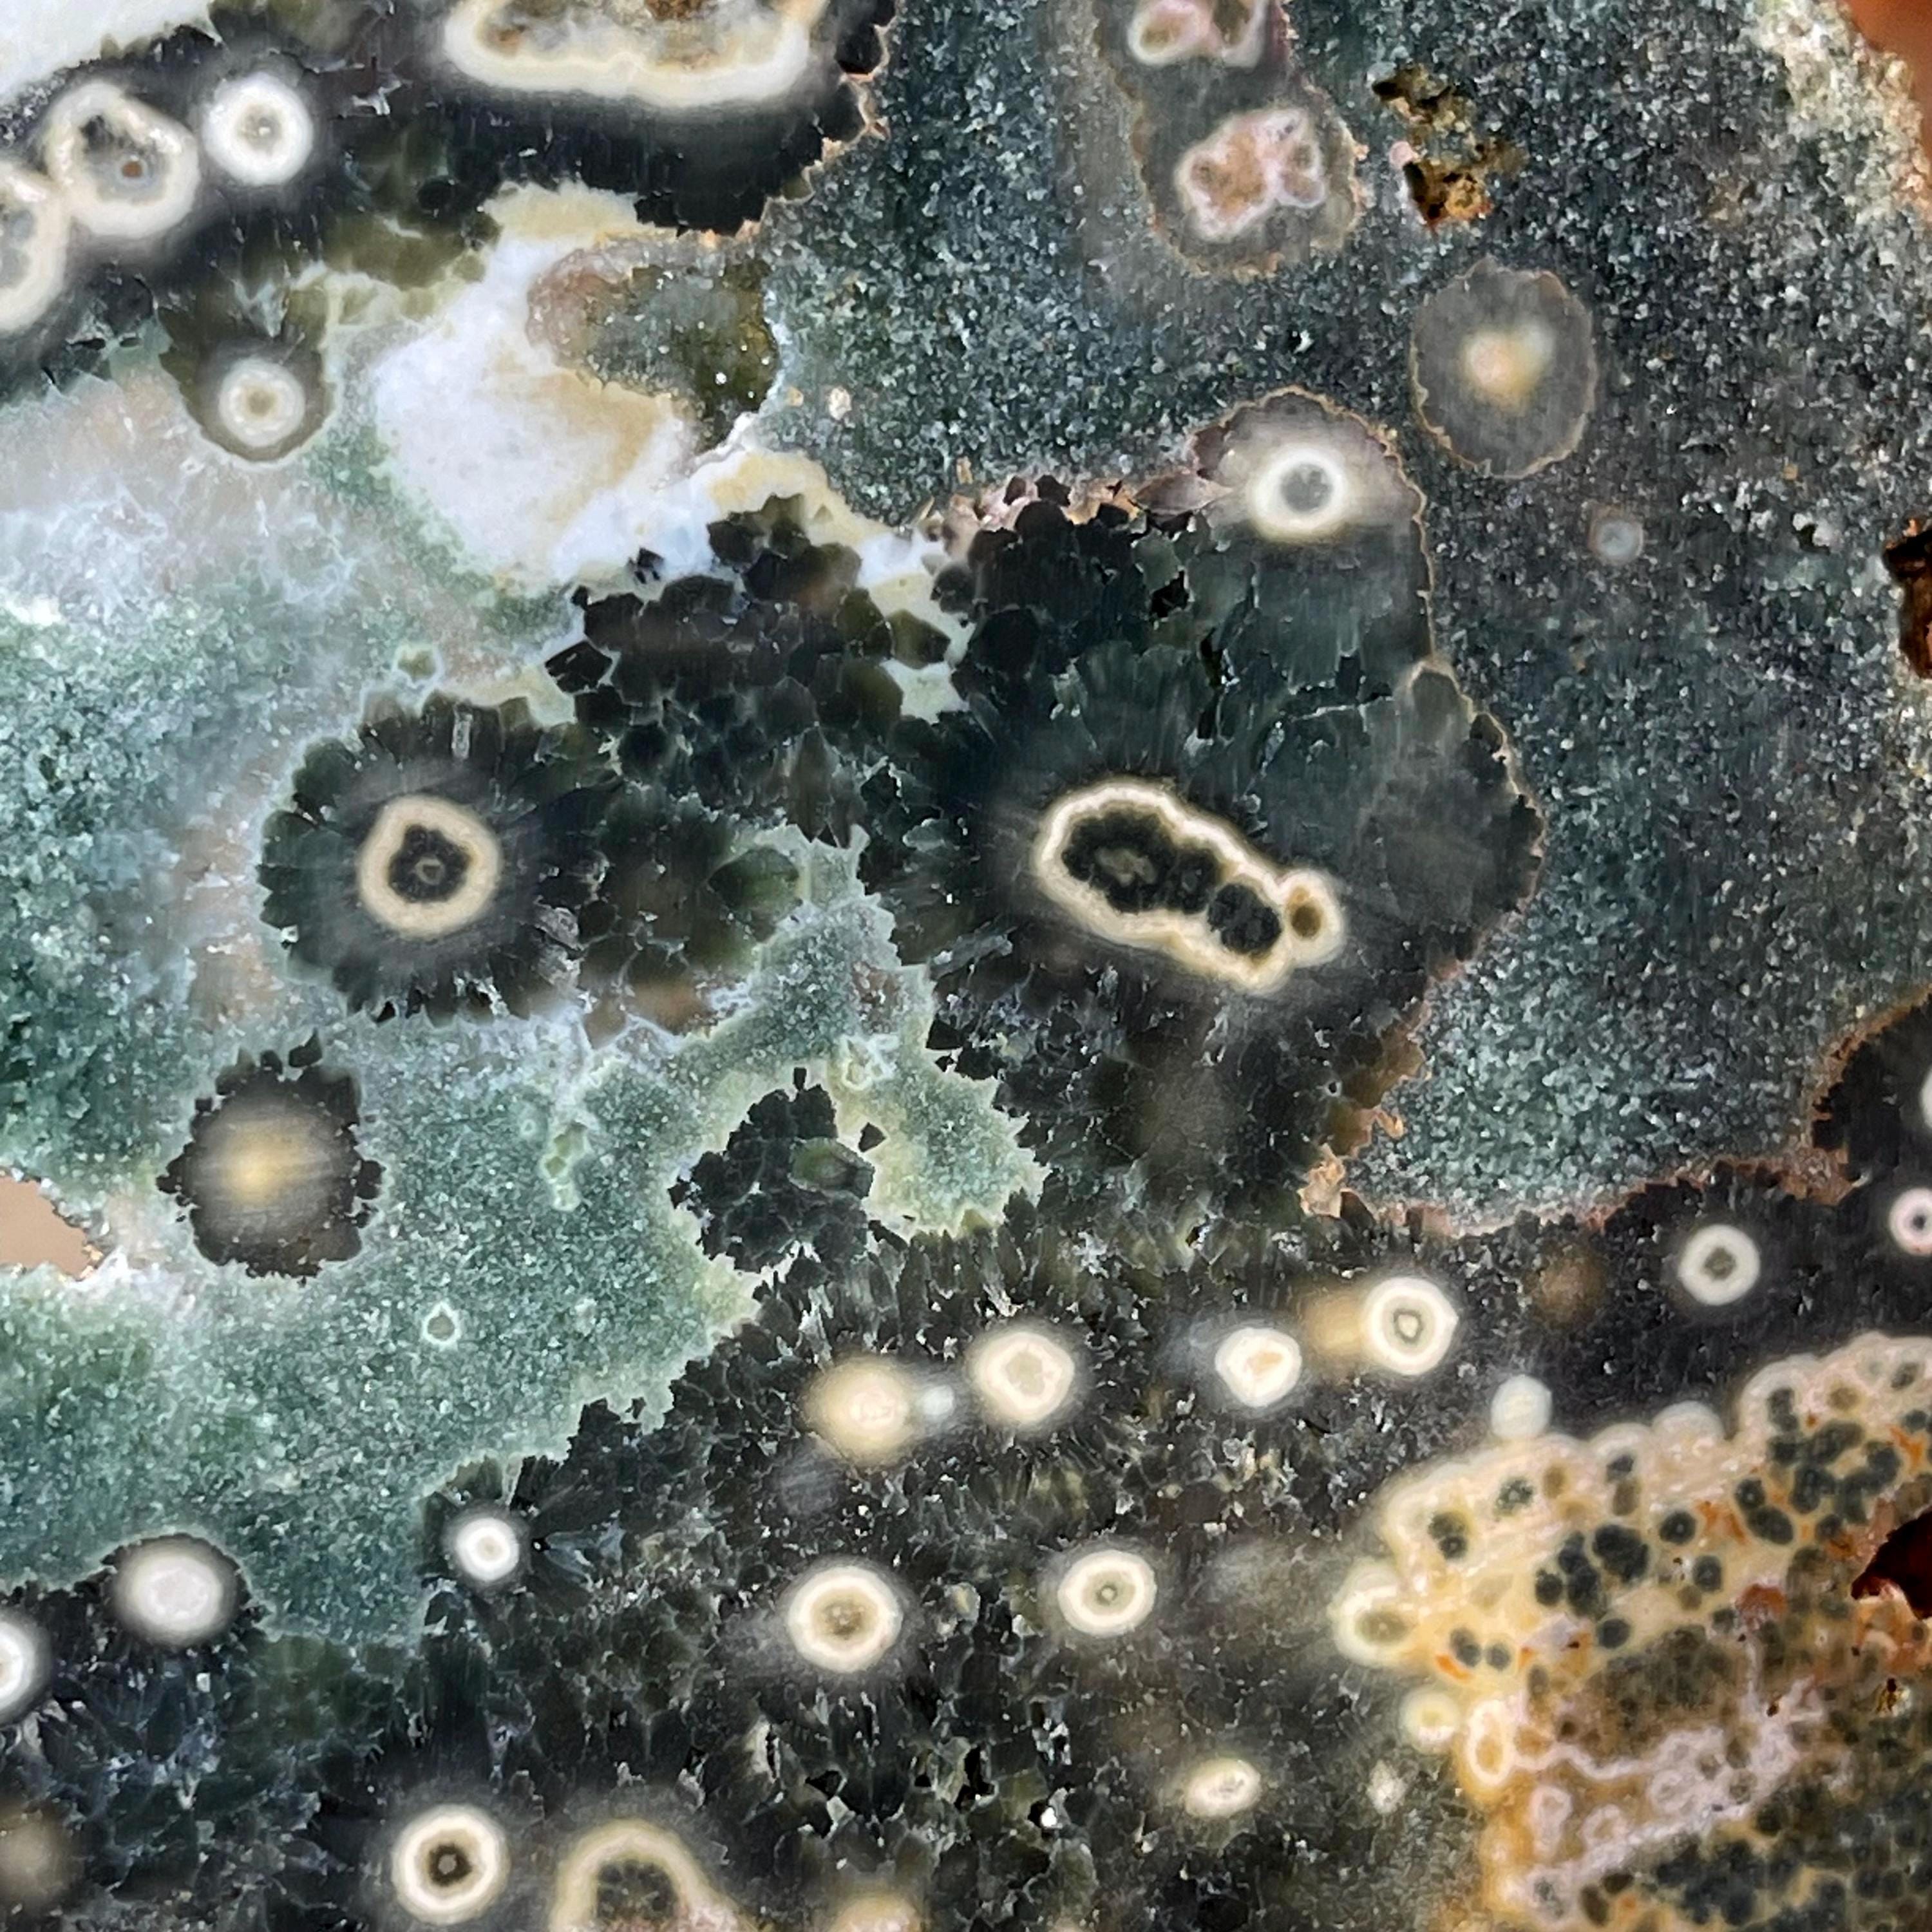
gallery photo

Ocean Jasper Slab
➡️ Not Polished ➡️ You will receive 1 pictured crystal ➡️ Size: approximately - 5.5 inches .
➡️ 1 pictured crystal
This gem is also an ideal gift for crystal enthusiasts. Whether used for meditation, jewelry making, decor, or as a meaningful keepsake, this crystal is a beautiful and functional piece of nature's artistry. ➡️ **Notice:**
Thank you for choosing my small business! Before making your purchase, please take a moment to read the following important information:
1. **Product Descriptions & Images:**
- Please carefully read all product descriptions and review all 10 pictures and measurements provided. Some images are enlarged to show details.
- If you have any questions or need further clarification prior to purchase, feel free to reach out to me. I am here to assist you!
2. **Color Variations:**
- Please note that there may be slight differences in color under different lighting conditions and due to variations in display/screen settings.
3. **All Sales Are Final:**
- I do not accept returns, however exchange is available ( see return/exchange policy). Once your order is shipped, I’m not responsible for any damage that may occur during transit by the carrier.
4. **Natural Variations for Intuitive Crystals:**
- Each stone is a unique creation of nature. Some gems are delicate and should be handled with care. You may notice differences in hue, shape, and size from piece to piece. This is part of their natural beauty!
5. ** Customs Fees Tariffs and Taxes :**
- I am located in Maryland, USA . If you are shopping and shipping within the US you are only responsible for your state taxes. International shipping Canada only please refer to your countries Fees and Tariffs for any additional fees and taxes.
➡️ If you have any questions or concerns, please do not hesitate to contact me. I am happy to help!
Thank you for your understanding and support. Happy shopping ! 🛍
Shipping from United States
Processing time
2-3 business days
Customs and import taxes
Buyers are responsible for any customs and import taxes that may apply. I'm not responsible for delays due to customs.
Payment Options
Returns & Exchanges
Exchanges accepted within 7 days
Buyers are responsible for return shipping costs. If the item is not returned in its original condition, the buyer is responsible for any loss in value.
The following items can't be returned or exchanged
Because of the nature of these items, unless they arrive damaged or defective, I can't accept returns for:
- Custom or personalized orders
- Perishable products (like food or flowers)
- Digital downloads
- Intimate items (for health/hygiene reasons)
- Items on sale
Privacy policy
Privacy Policy
Your privacy is important to us. We only collect personal information necessary to fulfill your order, such as your name, shipping address, and email address.
We do not share your personal information with any third parties, except as necessary to fulfill your order (e.g., shipping carriers).
We may use your email address to send you order updates.
If you have any questions about our privacy policy, please contact us.
Frequently Asked Questions
Is any of your pictures color corrected or use special lighting ?
We do NOT manipulate our pictures in any way. No fancy lights are used , just indoor or outdoor lights. We try to take as many pictures as possible from many different angles. We also have no issues with making a video of the actual item to show it live. Thank you
Can I get a refund ?
Unfortunately we do not accept returns , but you can exchange your item for another item in our store. There are no refunds. Exchange Policy is as follows: Conditions of returning your order for an exchange only ( no refunds ).
• Buyer can exchange this item for any other item in our shop of the same value
• Buyer must return item within 7 days of delivery
• Buyer is responsible for return shipping costs
• Buyer is responsible for loss in value (as agreed upon with seller) if an item isn't returned in original condition. Thank you 😊
International shipping prices?
All international shipping charges include priority shipping and insurance. International buyers are responsible for any additional charges set by your countries customs . If your order is returned to us an additional charge will charged again to ship it back to you. There will be a restocking fee of 10% if the order is returned to us.
International Buyers – Please Note: Import duties, taxes, and charges are not included in the item price or shipping cost. These charges are the buyer's responsibility. Please check with your country's customs office to determine what these additional costs will be prior to buying.
Size of gems stones and crystals ? How can I tell how big or small they are?
The ruler 📏 is provided in our photos for MM / INCH size so you can see EXACTLY how big or small the items are. We take pictures of our gems and now also have video for some of them. We also try to show the sizes again a human hand to give perspective and show the size. If there is a gem , crystal that you like and still unsure of the size please reach out and we will make a video just for you to try and give you a better understanding as to how big or small they are. Thank you 😊
Are the actual items in your pictures
We take pictures of the actual item you will receive. If you see something you like , you can always ask for a video of it and we will gladly provide you with it. Thank you
Who pays for customs fees/ taxes?
Buyers pay the additional costs such as duties, taxes, and customs clearance fees. Import charges can vary widely but are most commonly based on the price and type of item, package weight and dimensions, origin country, and the taxes, duties, and fees of the destination country.
Most sellers on Etsy are unable to predict which of these fees, if any, will be applied, and Etsy does not expect sellers to calculate or collect these fees or taxes.
How do you ship orders?
We ship USPS priority or USPS priority international only. Please note this information:
USPS makes the recipient responsible for customs duties and taxes and fees.
According to the USPS website
Please see our shipping policy.
International buyers
International Customers: Your order may be subject to import duties, custom tariffs or VAT charges. They vary greatly from country to country and we strongly suggest checking your country's customs policy. These charges are always the responsibility of the recipient/buyer . Please use this calculator http://www.importcalculator.com/ to see your counties charges. Thank you
Cabochon cut gemstone
Cabochon cut Gemstones are not calibrated and will have imperfections as they are only polished and shaped. They are not the same as faceted Gemstones that have a great cut and polish. Cabochon Gemstones will have imperfections, inclusions and surfaces that are not perfectly flat , round, oval or proportionally symmetrical. Please review ALL pictures, ASK questions and REQUEST video before purchasing as we do not offer refunds ( please review our return policy), only exchange is available. Thank you
Gemstone Certifications
Gemstones can be certified through GIA at an additional charge starting at ($100+) plus S/H to send to the GIA if you wish to get an official certificate . We work with trustworthy gem dealers, but certifying each stone in our inventory would be impossible and cost prohibited . Also all Gemstones listed in our store are sold as loose Gemstones.
